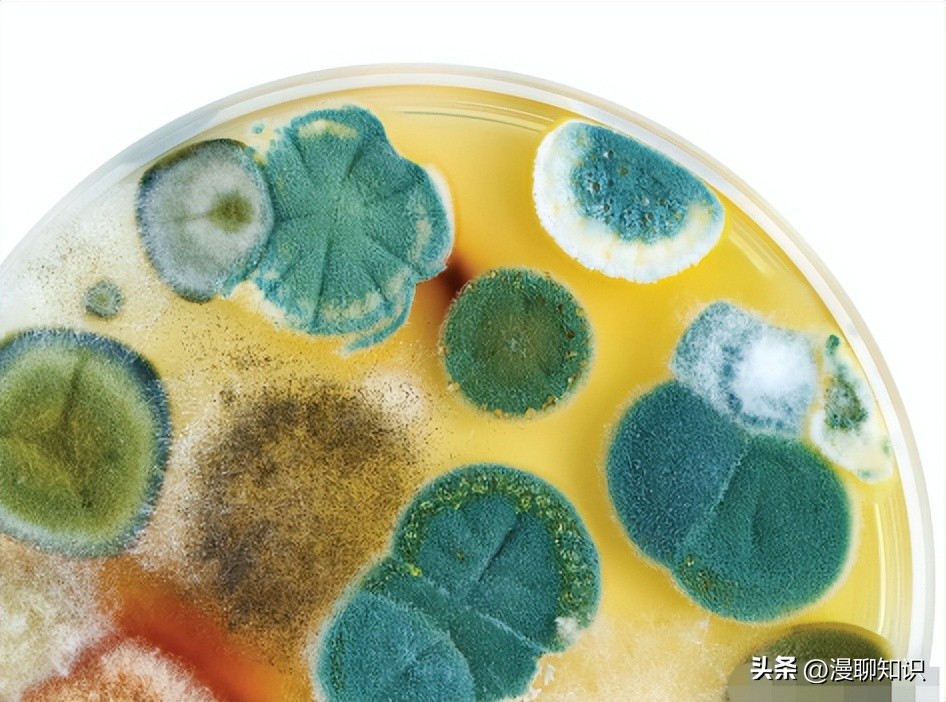
生物膜有害吗,生物膜有什么用

阅读文章前,辛苦您点下右上角的“关注”,方便您讨论分享,持续关注每日优质内容~
生物膜的存在因影响热传递从而影响了杀菌效果,例如芽孢杆菌(Bacil‐lus)在形成生物膜的过程中被分泌的黏性物质包裹增加了阻热能力,因此高压灭菌的时间需要增加几小时才能够达到同样的灭菌效果。
生物膜内的细菌比浮游细菌更难消除,因此,它们成为工厂、产品和人员反复污染的来源。
一饮料工厂因停产数月细菌在管路中形成生物膜,再次生产后持续出现产品污染事件,因管路中粗糙接口及自身分泌物质的保护,高温杀菌也未能彻底将其去除,调查后发现形成的生物膜中包含多种细菌,生产的饮料有酸性产品也有含糖量较高的产品,呈现机会污染特征,生物膜内细菌根据自身适宜条件选择性的在不同品类产品中增殖。
目前食品工业中较常见的消毒灭菌方式为臭氧灭菌、二氧化氯气体灭菌、过氧乙酸以及次氯酸钠等消毒剂。
但有研究表明臭氧、含氯气体杀菌方式、紫外照射以及使用75%酒精均不能彻底清除已形成的生物膜,300ppm浓度的过氧乙酸需要作用40min以上才能清除3log值以上的嗜酸耐热菌,使用1800ppm浓度的次氯酸钠作用40min也未能有效降低3log以上的嗜酸耐热菌,对于形成的生物膜杀菌效果不显著。
寻找安全有效、残留危害小的消除生物膜方式对于食品行业至关重要,目前常用的生物膜控制方式主要分为物理控制法、化学控制法、生物控制法、联合控制法。

针对食品接触面已经形成的生物膜,可以采用物理的方式进行去除,某些产品如生物、化学类的方式可能会对肉类的风味、感官造成影响。
近些年研究较多的控制生物膜的物理方法主要有超声法(ultrasound)、超高压(high hydrostatic pressure)、大气压冷等离子体法(atmospheric cold plasma)。
在食品加工业通常采用高强度超声产生的稳定空化对生物膜造成损伤,从而达到抑制其生长的作用,超声处理的生鲜肉、肉制品均能够有效地抑制生物膜的形成,延长食品保质期。
超高压(300MPa~900MPa)处理能够破坏芽孢子以外其他细菌细胞,相较于其他高温处理方法能够更好地保持产品的感官及营养特性。
林琳等人的研究表明,借助大气压冷等离子体技术在400W的功率下处理3min能够清除户太葡萄、圣女果、维多利亚青提及生菜四类果蔬表面已形成的90%以上的E.coli O157∶H7生物膜。

化学控制法适用于浮游细菌及已经成熟的生物膜,对微生物的继续繁殖也有一定的阻断作用。
常用的化学类试剂分为无机抗菌剂,如过氧化氢、次氯酸钠等食品加工环境常用消毒剂,具有广谱抑菌作用,但因其长期使用后微生物产生的抗性作用以及形成生物膜成分对其起到的阻挡作用,消除生物膜的作用并不理想,并且可能会增强某些微生物的成膜能力,如沙门氏菌。
近年来研究较多的为另一类有机抗菌剂,包括有机酸、季铵盐类、天然植物精油等,相较于无机抗菌剂,不易产生耐药性并且应用于食品加工行业中安全性更高。
乳酸、苯乳酸能够有效抑制食源性腐败菌阴沟肠杆菌、粪肠球菌生物膜的形成,亚抑菌浓度下减少胞外多糖的合成,抑制菌毛基因的表达,降低其泳动能力。
天然酚类精油,如香芹酚、百里香酚等,同样也能够抑制细菌多糖的分泌以及菌体初期的黏附。

抑制生物膜的生物控制方法集中于酶破坏、噬菌体以及抑制群体感应系统方面。
生物膜的主要成分是有机大分子(主要是蛋白质和多糖),蛋白酶和糖苷酶可作为去除生物膜的首选,例如果胶甲基酯酶是一种能够减少生物反应器中生物膜形成的酶,且具有可生物降解、低毒性的优点,因此,可用于食品工业使用的机器、管道的消毒处理。
也可以利用噬菌体侵入菌体过程中编码的酶类裂解已形成的生物膜,例如解聚酶就可以分解大部分多糖类物质。
并且噬菌体的抗菌活性对人类、动物和植物都是无害的,因为它们仅杀死原核细胞。
群体感应是一种广泛分布于细胞间的信号传导机制,细菌借助群体感应调节基因表达,以响应高环境浓度的小扩散信号分子,基于这一特性,可以通过控制细菌间的群体感应系统进而抑制生物膜的形成。
邢家溧等人的研究表明3,4-二溴-2(5H)-呋喃酮作为群体感应*制剂抑**在5MIC(最小抑菌浓度)的作用下24h内能够抑制99.54%±1.83%荧光假单胞菌生物膜的形成。

单一种类的抑制方法作用有限,因此有时需要多种方式联合才能起到更好的效果。
例如超高压处理对能产生孢子的微生物无效,食品加工采用超高压处理后可能仍然残留着未萌发的孢子,此时需要配合其他方式使孢子萌发后再使用超高压处理,才能有效去除这类微生物形成的生物膜。
将超声与热处理结合与单独超声或单独热处理相比有更强的杀菌效果,破坏金黄色葡萄球菌生物膜内菌体细胞的完整性,引起其细胞膜通透性的变化,从而达到协同杀菌的作用,降低由金黄色葡萄球菌生物膜形成引起的鸡肉腐败以及食源性致病菌的传播。
使用超声技术与有机酸的结合使用,能够降低杀鲑气单胞菌生物膜内菌体细胞内呼吸链脱氢酶活性,协同降低胞外聚合物的产生,降低虾类、鱼类、禽类被杀鲑气单胞菌生物膜污染的风险。

细菌生物膜包含破坏食品的物质和致病细菌,即使经过了处理仍然会导致食品污染,从而降低产品质量、缩短保质期,也可能成为疾病传播的一种方式。
因此,必须有适当的方法来防止细菌生物膜的形成或彻底清除,以防扩散到食物和加工表面上。
针对生物膜的控制有三种不同的策略:1)在生物膜形成之前“及时”消毒;2)使用强作用力的消毒剂对生物膜进行消毒;3)选择不易于附着或不利于营养传输的表面物质来抑制微生物的附着。

食品接触面很容易因其水分和养分丰富形成生物膜,所以保持干燥和清洁的环境至关重要。
良好的清洗过程可以去除食物残渣和其他化合物,防止营养物质的积累,从而降低生物膜形成的条件。
就地清洗(Clean in place,CIP)是一个无需手动拆卸或由人员操作即可清洗整个系统的过程,能及时有效地对设备进行清洗。
清洗过程中添加碱或酸可提高CIP对细菌生物膜的去除效果。
生物膜在适宜的p H值、温度、营养条件下易于生长,因此,为了预防生物膜的形成,可以通过控制环境条件达到效果。
生物膜的形成还依赖于群体感应系统,可以选择适宜的群体感应*制剂抑**阻断胞外聚合物的形成。

由于生物膜的结构、组成特性,想要去除已形成的生物膜,了解菌落的黏附和定殖的机制是至关重要的。
根据食品行业的不同,了解该行业常见微生物,才能够有针对性地选择切实有效的合适方法。
乳品生产中嗜热杆菌为主要污染源,因其耐热且能产生芽孢的特性,巴氏杀菌温度极难将其杀死,甚至有些种类嗜热杆菌芽孢可耐UHT杀菌温度,在营养丰富的条件下形成生物膜。
因此,针对这类微生物热处理不能达到清除生物膜的作用,目前常用的方法均为物理清除法。
掌握其特性后,可以考虑采用安全、无害、不影响产品品质的化学或生物控制法。

群体感应的信号分子触发生物膜释放扩散,生物膜的分散既受环境因素的影响,又受群体感应的调节,因此防止扩散依赖于对环境因素和感应信号的控制。
在物理控制法不能彻底去除生物膜时,需要借助化学、生物或联合抑制的方法,通过破坏生物膜内细菌的结构或影响其基因表达阻断生物膜形成的进程。
食源性病原体可以附着在许多食物基质和环境表面上并产生胞外聚合物,病原菌也可以与环境中其他的微生物共存于生物膜环境中。
细菌生物膜的形成不仅取决于基因表达和调控,还取决于基质和细菌细胞的特性,还包括温度、p H值、表面性质等在内的环境因素。
因此在食品生产中对生物膜的控制应依据其生长特性展开,在对生产卫生、运行生产线、清洁和消毒剂使用的控制时提出更有效的措施来延缓生物膜的生长和减少产品污染,以提高产品的质量和安全性,寻求理想的、具有成本效益且不会对人类健康和环境产生任何不利影响的方法。